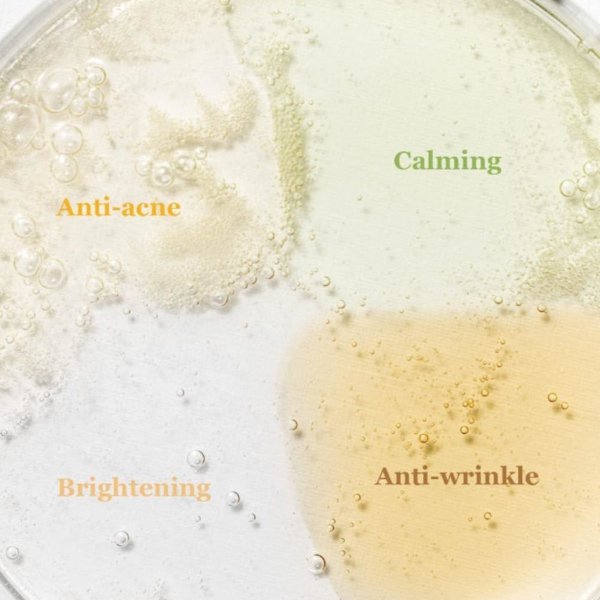

Beauty Of Joseon Hanbang Serum Discovery Kit
- Trial-size kit from the whole Beauty of Joseon’s serum line .
- Revive Serum: Effectively repairs damaged skin and helps improve wrinkles as well as skin elasticity.
- Glow Deep Serum: Lightweight and watery texture promotes absorption and gives delicate skin hydration with comforts.
- Glow Serum: Promotes effective treatment for acne problems.
- Delivery & Return
Delivery
We ship all over the UK. All orders are shipped with a Royal Mail tracking number. During sale periods and promotions the delivery time may be longer than normal.Return
Tetra Cosmetics will accept exchanges and returns of unused and unopened products within 7 days of the date of purchase. Cost of returns made to us is the buyer's responsibility. Any items that are returned must be done so in their original packaging and must be sent to us in fine condition. If not, we reserve the right to not issue a refund. However, should you not be satisfied with any goods you have received, please let us know so that we can find a suitable solution. Your return will usually be processed within a week to a week and a half. We’ll send you a return notification email to notify you once the return has been completed. Please allow 1-3 business days for refunds to be received to the original form of payment once the return has been processed.Help
Give us a shout if you have any other questions and/or concerns.- Email: support@tetracosmetics.co.uk
- Phone: (+44)-750-7969-524
£18.00 Original price was: £18.00.£14.49Current price is: £14.49.
Out of stock
The Beauty of Joseon Hanbang Serum Discovery Kit contains all of your favorite serums in one set. With this set of minis, you can try all of Beauty of Joseon’s serums to see which are best for you.
- Calming Serum : Green Tea + Panthenol (10ml / 0.33fl.oz.)
- Glow Serum : Propolis + Niacinamide (10ml / 0.33fl.oz.)
- Glow Deep Serum : Rice + Alpha-Arbutin (10ml / 0.33fl.oz.)
- Revive Serum : Ginseng + Snail Mucin (10ml / 0.33fl.oz.)
| Weight | 100 g |
|---|---|
| Dimensions | 8 × 12 × 3.5 cm |
Based on 0 reviews
|
|
|
0% |
|
|
|
0% |
|
|
|
0% |
|
|
|
0% |
|
|
|
0% |
- Advanced Clinical Vitamin C
- Advent Calendar
- Amazon
- Anti-Ageing
- boots
- Bukhoor
- Christmas Gift Set
- Concealer
- eBay
- Eyebrow
- Eye Makeup
- Face Make-Up
- Face Powder
- Fertility Support
- Foundation
- Gift Set
- Hair Colour
- Hair Styling
- Korean Beauty Product
- Lip Balm
- Lip Liner
- Lipstick
- Liquid Lipstick
- Makeup Sponge
- Mascara
- Max Factor
- Nail Care
- Perfume Gift Set
- Perfumes
- Personal Healthcare
- Pregnancy Support
- Skincare
- Superdrug
- TikTok Trends
- Unisex Fragrance
- Volume Million Lashes
Related Products
- Unique concentrated formula of collagen, retinol and vitamins to help restore natural plumpness & elasticity.
- Helps to soften fine lines and revive skin’s natural radiance.
- Acacia collagen plumps skin & boosts elasticity.
- Peptides retain moisture while chamomile soothes skin.
108 in stock
Out of stock
- 96% natural origin ingredients
- 96% readily biodegradable ingredients
- Made with Protect destination-of origin Lavender from Provence
3 in stock
- 97% natural origin ingredients
- 98% readily biodegradable ingredients
- Made with 100% traceable Mediterranean almonds
3 in stock
- Micellar Soothing Formula: Amino Acid Complex + Dexpanthenol create a gentle skin cleanser with a soothing and hydrating effect that leaves skin clean and calm
- Effective cleanser: Enriched with Micelles, this Micellar Water and gentle skin cleanser effectively removes makeup, impurities, and dirt. Ideal as an eye makeup remover
- Dermatologically tested: NIVEA Micellar Water, a perfume-free and gentle face cleanser, is dermatologically and ophthalmologically tested and can be used as an eye makeup remover
Out of stock
Out of stock
- Guarantees high protection against UVA and UVB rays.
- Intensely moisturises.
Out of stock
- Hydration station
- Designed to smooth and soften hands
- Cherry extract and anti-inflammatory shea butter work to soothe and hydrate skin
- Suitable for all skin types
- Non-greasy formula
12 in stock
- Rose Floral Water: recognised for its soothing and softening properties on all skin types, including sensitive skin.
- 100% botanical-origin Skin-Respect Complex: consisting of Moisturising Sugars, it hydrates and strengthens skin’s protective barrier.
- Micellar cleansing agents: to effectively remove impurities and make-up while ensuring skin tolerance
Out of stock
- SPF 30+ for broad-spectrum sun protection
- UVA and UVB filters guard against sun damage
- Intensely moisturizing formula
- Enriched with Hyaluronic Acid to hydrate the skin
- Lightweight and non-greasy texture
- Suitable for daily use
- Long-lasting formula
- Dermatologically tested
- Paraben-free
- Suitable for all skin types
Out of stock
- A 7 day collagen cure for stronger and retightened skin in 1 week
- Specifically formulated in laboratories for mature women
- Our Collagen Amino Acid Fractions help to firm and retighten skin
Out of stock
- Vegan-Friendly
- 98% natural origin ingredients
- 99% readily biodegradable ingredients
- Made with Organic Fair-Trade Verbena from Provence
45 in stock

Reviews
There are no reviews yet.